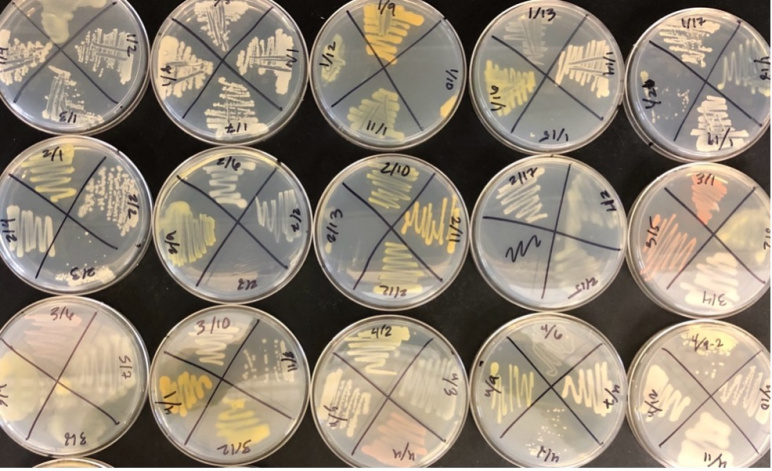
Soil samples in petri dishes photographed from above

Our Research Food security in Africa through microbiome engineering

Maize roots.

Growth chamber to image an intact, growing, plant root system.

Metabolic imaging (You Lab) of Arabidopsis roots under different environmental stress in situ (McRose Lab). This preliminary image shows the metabolic contrast within the root without destructive slicing or staining.
Soil bacteria like the ones shown here growing on plates often produce metabolites that can help release phosphorus from iron minerals. In this image, the different colors are very likely bacterial metabolites. Photo Credit: Darcy McRose.
Principal Investigators
Christopher Voigt
- Daniel I.C. Wang Professor of Advanced Biotechnology
- and department head
- Department of Biological Engineering
David L. Des Marais
- Cecil & Ida Green Career Development Professor
- Associate Professor of Civil and Environmental Engineering
- Department of Civil and Environmental Engineering
Tami Lieberman
- Associate professor
- Department of Civil and Environmental Engineering
- Institute for Medical Science and Engineering
Darcy McRose
- Thomas D. and Virginia W. Cabot Career Development Assistant Professor
- Civil and Environmental Engineering
Tavneet Suri
- Louis E. Seley Professor of Applied Economics
- MIT Sloan School of Management
Sixian You
- Assistant Professor
- Department of Electrical Engineering and Computer Science
Challenge:
Can we replace agricultural inputs derived from synthetic chemistry with those that can be delivered by microbes, applied at planting?
Research Strategy
- Catalog microbial species from crop roots from farms in the U.S. and Kenya, in collaboration with Kenyatta University, and isolate and engineer nitrogen-fixing bacteria to do so continuously with cereal crops
- Build consortia that coat the roots of plants and are maximally metabolically active. Success will be measured by lower plant-to-plant variability, higher total activity, and stability of the consortium against stresses and environmental conditions
- Work with the Jameel Poverty Action Lab (J-PAL) and small stakeholder farmers to establish protocols for using microbial products. Best practices and networks to educate and train farmers will be developed, along with the distribution requirements to transport active bacteria for testing and use
Project description
Agrichemicals, including herbicides and fertilizer, are essential to obtain the crop yields required to feed the world. However, in their chemical form, they are responsible for most of the air and water pollution from agriculture. Microbes have the theoretical ability to replace the functions of agrochemicals, but the challenge has been poorly understood variability between plants and farms. In this project, the team will address this problem by analyzing microbial communities present in soil across diverse farms in the U.S. and Kenya. Data will be obtained to rationally combine species into stable consortia that reliably coat the root and maximize their agricultural function(s). Each species within the consortium offers the capability to enhance activity through redundancy or introduce multiple functions. Consortium design will be applied to the goal of increasing microbial nitrogen delivery to a cereal crop, while reducing variability. Beyond these specific applications, a successful platform to have bacteria reliably deliver traits to crops could increase yields while reducing water use, energy requirements, and environmental impact.
The MIT team will work with Kenyatta University collaborators. They include professors Richard Oduor, Jayne Mugwe, John Maingi, Njeri Mugwe, and Ezekiel Mugendi. This group possesses complementary expertise in soil analysis, characterization of microbial content, and the isolation of nitrogen fixing strains from Kenyan farms.
News
Additional Details
Impact Areas
- Food
- Climate & Sustainability
Research Themes
- Technology & Commercialization
- Sustainability & Adaptation
- Soil Fertility & Crop Productivity
- Economics, Policy, & Practices
- Transforming Food Systems
- Equity & Access
Year Funded
- 2025
Grant Type
- Grand Challenge Grant
Status
- Ongoing

